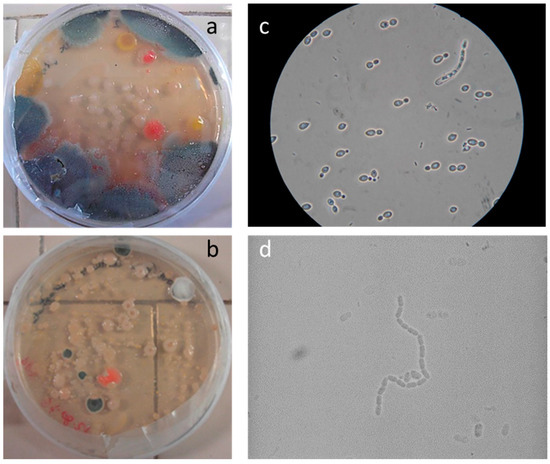

Abstract
“Atmospheric” painting stands as a new frontier in contemporary art, presenting challenges and new considerations in museum practices. This article aims to analyze the possible evolution of four atmospheric paintings created by artist Luca Vitone during their transition from exhibition halls to the storage facilities of the MAXXI museum. The presence of active microbiological consortium raises question regarding the potential interaction these artworks may have with the surrounding environment. The year-long monitoring involved macroscopic and microscopic observation, spectrophotometric analyses, and cell vitality assessments using a bioluminometer. Additionally, the collected data were correlated with the prevailing microclimate within the storage. Indeed, the canvases underwent an evolution during their transfer to the storage; it was mainly the photosynthetic part of the consortium that underwent the greatest changes, resulting in changes in the color tones of the canvases. The viability of the cells in the consortium also underwent changes as indicated by measurements obtained with the bioluminometer. The monitoring has provided invaluable insights into the dynamic evolution of Vitone’s artworks and allowed the authors to hypothesize some strategies for the conservation of these types of artworks.
1. Introduction
Conceptual approaches continue to change traditional concepts in the field of art. “Atmospheric” painting is one such innovative technique that introduces a new perspective to the relationship between artistic expression and the natural world. The line between art and the unpredictable nature of weather patterns becomes blurred when artists draw inspiration from the atmospheric conditions around them, producing artworks that surpass the conventional limit. The concept of purposeful weathering as an artistic technique has gained popularity among modern painters. The weathering process is transformed into an artistic journey when artists use rusting, oxidation, biological degradation, and chemical reactions as a medium to produce distinctive textures and patterns. The relationship between art, weathering, and the preservation of cultural property is deeply questioned by this deliberate engagement with the environment [1,2]. Within this context, the unconventional artworks by Luca Vitone exemplify the fusion of artistic expression and atmospheric influence [3]. Canvases of the “IO, VILLA ADRIANA” series strategically placed in Hadrian’s Villa capture the essence of their surroundings, becoming self-portraits of the environment itself. Yet, this intentional exposure also invites the colonization of artworks by microorganisms, adding an unpredictable layer to the canvas [4,5]. Due to the nature of these artworks, the biological transformation of the matter becomes an integral part of the artistic process, bringing the artwork to life. The beauty of the conceptual form, however, contrasts with the need to preserve these types of artworks within the exhibition and storage space of the museum. Different groups of microbes adhere to and develop on cultural artefacts according to the chemical composition and environmental factors [6,7]. Microorganisms that colonize surfaces of cultural heritage can alter the underlying materials through their influences on the physical, chemical, and bioreceptivity of the substratum materials, especially through metabolic activities and chemical reaction [7,8]. Additionally, the amount and quality of metabolites such as organic acids produced by microorganisms growing on various substrates varies, making it difficult to determine whether the presence of a microorganism detected through DNA sequencing poses a biodeteriogen risk for the substrate [7,9]. Due to their high level of environmental tolerance and their physiology, fungi are particularly harmful. Additionally, they create spores that are easily disseminated by moving air and require less relative humidity (RH) and temperature range (T°) for development than bacteria [10,11,12]. Fungal spores can easily be transported by air conditioning or handling an object. Furthermore, through direct contact, air movement, or chemical vapors, possible nutrients for the microorganisms can be transported from one thing to another in proximity, thus making the storage of peculiar artworks, like the Vitone’s canvases, even more difficult and their monitoring a crucial point in their conservation [13,14]. It was found that ranges of parameters, as opposed to specific values, should be defined as the best values for the protection of artworks [15,16,17]. A few factors, such as the number of objects per square meter and the nature and degree of conservation of the artworks, should be taken into consideration to decide which are the best conditions for a particular museum or storage facility [10,18,19].
The aim of the study was to track the changes in the aesthetic appearance due to the microorganism vitality on four distinct canvases of the “IO, VILLA ADRIANA” series in response to variations in the temperature, relative humidity, and lighting system as a result of their relocation in the MAXXI museum storage in Rome. During a year, macro and micro photographs of the surface were acquired, during four different monitoring campaigns, using both induced UV fluorescence and visible light to follow the description of the conservation state of the artworks and the biofilm.
Measurements of the temperature, relative humidity, and lighting in the warehouse were collected as influencing factors on microbial vitality. Spectrocolorimeter data of the canvases’ surfaces were acquired to assess the extent to which the evolution of the microbial consortia influences the artwork’s aspect visibly to the observer. A bioluminometer was used to measure RLU values to assess the microbial cells’ vitality.
The article represents the first monitoring of these artworks during their transfer in the museum storage.
These artworks are part of a group of nine large canvases (dimension about 3 × 2 m), which the artist Luca Vitone placed around the archaeological site of Hadrian’s Villa, in Tivoli, near Rome. The blank canvases have been placed under the ground or hung on vertical surfaces outdoors and left exposed to atmospheric agents for over a year to be in contact with the surrounding environment. The weather, along with the micro- and macro-flora and fauna of the place, have imprinted their image on the raw material, in the form of deposits, stains, oxidations, and biofilms, thereby producing self-portraits of the emperor’s residence. After this creative process was completed, the canvases were left to dry and then cut and mounted on light wooden frames.
The canvases were first displayed together, in a room of the MAXXI museum in Rome, during the exhibition “Io Villa Adriana” (June–September 2021) carried out in collaboration with MAXXI and Institute of Villa Adriana and Villa d’Este-VILLÆ. Three canvases are actually part of the permanent collection of MAXXI; one has been acquired into the VILLÆ permanent collection (Luca Vitone. Io, Villa Adriana, a cura di Anne Palopoli; testi Andrea Bruciati, Giulia Floris, Costanza Morabito, Anne Palopoli, Bartolomeo Pietromarchi, Marco Scotini; Quodlibet, 2021).
On this occasion, during the exhibition dismantling, the need to think about the evolution and conservation of these artworks emerged, thus stimulating the long monitoring process presented here.
2. Materials and Methods
The study was focused on artworks shown in Table 1, during the period September 2021–September 2022, through four monitoring campaigns (September 2021–December 2021–May2022–September 2022) using the following non-destructive and non-invasive analytical investigations:
- Microbiological analysis to define the viable microbial consortium on the canvas.
- Macroscopic images acquired in visible light to document the variation in the aspect of the surface.
- Surface observation in portable digital optical microscopy at different magnifications—from 40× to 220×—and illumination modes—visible light (VIS) and ultraviolet light (UV), was used to define the surface morphological characteristics and document the microorganisms present in the microbial community.
- A bioluminometer, a portable instrument to measure in situ the amount of ATP (adenosine triphosphate), a molecule present in all living organisms, reflecting the biological contamination degree on the areas under examination.
- Spectrocolorimetry, used to analyze the chromatic variations induced by the evolution of the microbial consortium.
The canvases intended for storage have been enveloped in Tyvek® (DuPont), a totally synthetic fabric made of high-density polyethylene fibers. The choice was dictated by the characteristics of the material: it is very lightweight and durable as well as water resistant, but at the same time breathable. According to the manufacturer, Tyvek® provides outstanding resistance to microbial penetration [20].


Table 1.
List of artworks subject to monitoring.
Table 1.
List of artworks subject to monitoring.
 |  |
| Canvas ID: 2, title: Veduta di passeggiata pensando al Pecile. Io, Villa Adriana | Canvas ID: 5, title: Paesaggio visto dalle Piccole Terme. Io, Villa Adriana |
 |  |
| Canvas ID: 6, title: veduta del Canopo da due finestre. Io, Villa Adriana | Canvas ID: 9, title: veduta di Camerino presso il Canopo. Io, Villa Adriana |
| Courtesy: FondationMAXXI (Canvases 2, 5, and 9) Courtesy: Institute of Villa Adriana and Villa d’Este—VILLÆ (Canvas 6) Photo: Francesco Marsili | |
2.1. Microbiological Analysis
The samples collected via dry swab were stored both in sterile tubes containing 4 mL of physiological solution (NaCl 0.9%) or dry. Moved to the laboratory, they were immediately applied to solid growth medium to verify the viability of the microorganisms and the type of contamination. Potato Dextrose agar (PDA) and liquid (PDB) was used as the medium for the development of the fungal flora; Tryptic soy agar (TSA) and broth (TSB) medium was used for bacteria enumeration. Two types of plate inoculation were used to highlight the vitality of the cultivable microbial flora in the most representative way:
- Direct smears of the sampling swabs (dry) on the solid media;
- Plates of 100 µL of liquid suspension, after 24 h of incubation of sampling swabs.
The same amount of liquid suspension was inoculated in liquid media.
The PDA and TSA plates were incubated at 28 °C in the dark and checked every 24 h. The morphotypes were isolated from the original plates to proceed with the possible identification of the contaminants. The liquid cultures in PDB and TSB were kept under stirring at 28 °C. After two days of incubation, control slides of the liquid suspensions were observed under an optical microscope Nikon Eclipse E600 (Nikon, Tokyo, Japan) equipped with a halogen lamp.
Isolate identification was performed using Biolog plates for fungi (FF microplates) according to the manufacturer’s procedure (Biolog Inc., Hayward, CA, USA) and incubated at 25 °C for up to 4 days. Patterns of substrate utilization for each strain were recorded with MicroLog software (version 6.2). Tentative identification was performed with the Biolog database for fungi and yeast.
2.2. Macroscopical Photographic Survey
Photographic documentation in visible light was acquired on the bottom-left corner in the front of all the different canvases, defying an area of 50 × 50 cm to document the state of conservation of the artworks before and after the handling operation using a digital camera (Samsung NX500—28.2 MP BSI CMOS, Samsung, Suwon-si, Republic of Korea) for a period of one year from September 2021 to September 2022.
2.3. Digital Optical Microscopy
A Dino-Lite AM411-FVW (Dino-Lite Europe, Almere—The Netherlands) optical portable microscope was used at different magnifications—from 40× to 220×—and illumination modes—visible light (VIS) and ultraviolet light (UV), to better highlight the conservation state previously observed with photographic documentation at the macroscopic level, allowing changes in the canvas’ surface in relation to the evolution of the microbial consortium to be highlighted. Table 2 reports, for each canvas, images of similar areas, comparing the results of the latest monitoring with the studies carried out in previous monitoring campaigns.

Table 2.
Images acquired in visible light of the different canvases during the four different monitoring campaigns. The images were acquired on the same area of the canvas (bottom-left corner in the front). The size scale below each photo represents 10 cm.
2.4. Microclimate Monitoring
A temperature (T), relative humidity (RH%) and light value (Lux) sensor (HOBO Temp/RH/Light/Ext-Analog Data Logger MX1104) was inserted in the box of each canvas. The aim was to monitor the microclimate conditions of conservation of the artworks to verify the development of conditions able to modify the microbial consortium.
2.5. Bioluminometer
The measurement (Lumitester PD-30 Kikkoman Bioanalitica Company, Tokyo, Japan) of relative light units (RLU) permits the presence of ATP molecules in the sample to be quantified. The instrument measures light emission, which can be linked to the number of ATP molecules. Furthermore, because ATP is a chemical molecule that only live organisms produce, the number of ATP molecules registered can be qualitatively connected to the number of living cells. For environmental studies, a value up to 3000 RLU means that there are only very few organisms alive on the surface; on the other hand, a high RLU value indicates a vital and active microbial community. The measurement of ATP in a logarithmic dilution series of bacterial cultures correlates with the number of bacteria present; hence, ATP testing offers an indication of bacterial contamination [19]. The data represent the average of the three different measurements of RLU taken on the canvas surface.
2.6. Spectrocolorimetric Analysis
Spectrocolorimetric analyses were carried out on the canvas to monitoring the chromatic variation in the paintings’ surface due to the evolution of the microbial community. To better understand the chromatic change in the surface and whether the changes were perceivable by the naked eye, the total color variation was calculated between the mean value of the last monitoring with the mean value obtain from the previous campaigns. The total color variation was calculated as:
The analysis was carried out with a 3 nh Y3060 spectrocolorimeter. The instrument can accurately measure the reflective data SCI (specular component included) and SCE (specular component excluded) and can express the measurements in various color spaces. Optical geometry: 8°, geometric optical lighting recommended by the CIE. Light source: full-spectrum combined LED light source, UV light source. The range of wavelengths is 400–700 nm. For the data display, the CIELab76 color space was selected. An extensive experimental study on perceptibility tolerances of pictorial images reproduced on CRTs has shown that the average perceptible difference lies in the range of ∆E < 5 [21,22,23].
3. Results and Discussion
3.1. Microbiological Analysis
To confirm the cell vitality, 24 h after plating on solid growth media, all samples developed a widespread microbial flora, consisting of fungi, yeasts, and bacteria (Figure 1a,b). A high number of cells was observed in the liquid suspensions by microscopy analysis. Several different fungal spores and hyphae and bacterial cells (mainly rods) were found in the samples from all the canvases (Figure 1c,d). On canvases 6 and 5 the microbiological analysis revealed a low biodiversity, with the dominance of bacterial colonies, whose morphology was attributable to Bacillus megaterium. On canvases 2 and 9, the growth of a complex population composed of fungi, yeasts, and bacteria was observed. The yeast colonies isolated from the samples of canvas 2 and 9 were identified as Serratia marcescens, a typical soil strain. The 13 isolated fungi were analyzed using Biolog FF microplates, and the comparison with the database returned the attribution to the genera Cladosporium (two strains), Acrodontium (five strains), Fusarium (two strains) and Penicillium (four strains), all common soil and air inhabitants, although Acrodontium is a genus less frequently found in these environmental matrices. The analysis confirmed the presence of viable microorganisms that could activate and develop in favorable environmental conditions. It is worth noting that canvases 2 and 9 (buried under soil) and canvases 5 and 6 (exposed to atmospheric agents) showed similar contamination in terms of cell count (from 1 × 102 to 6 × 102 colony forming units per square centimeter) and very few differences in the quality of the cultivable fraction (the presence of Serratia marcescens only in the buried canvases).
Figure 1.
Colony morphotypes grown on Petri disk with PDA inoculated with the sample collected from canvases 2 (a) and 9 (b). Cell morphology under optical microscope from canvas 6 showing the presence of yeast, bacterial rods, and fungal hyphae (c) and a typical Bacillus megaterium cell chain from canvas 2 (d).
3.2. Photographic Documentation
The photos acquired in visible light during the monitoring in December 2021, after the paintings were relocated to storage, are show in Table 2. They revealed no macroscopic variations in the surface aspect for canvases 2 and 6. However, important perception variations were observed for canvases 5 and 9. The aspect of the canvases shifted towards brown tones with a decrease in color saturation. During the monitoring campaign in May 2022, the images followed the previous trend: indicating no macroscopic alterations on the surface of canvases 2 and 6, while indicating a change in perceptions in the aspect of canvas 5 and 9. The images acquired during the September 2022 monitoring, after one year, displayed a change in appearance towards more lively tones for all canvases.
3.3. Digital Optical Microscopy
Compared with the macroscopic observations, the microscopical images acquired using Dinolite portable optical microscopy during the December 2021 monitoring revealed surface variations for canvases 9, 5, and 6, influenced by the evolution of the microbial community (Table 3). The microbial consortium has probably lost photosynthetic microorganisms, taking on a brown appearance. This result is due to the absence of light within the storage boxes where the canvases were placed. Observations carried out in May highlighted a decrease in the consortium and shift towards brown and dark tones in all studied canvases. During the September 2022 monitoring, the canvases showed a minor increase in chromatic saturation, suggesting the potential recovery of the microbial consortia vitality (Table 3).

Table 3.
Observations in optical microscopy (visible light) of similar areas in their respective canvases. The size scale below each photo represents 10 mm subdivided into 100 divisions of 0.1 mm (100 µm).
Observations conducted in visible light are confirmed by observations in ultraviolet light (Table 4). It is in fact possible to highlight the red fluorescence of the chlorophyll in canvases 9 and 2. The high fluorescence measured in September 2021 decreased, although it was still present in December 2021, disappearing completely in May 2022. In September 2022, only canvas 9 was characterized by weak fluorescence.

Table 4.
Observations in optical microscopy (UV light) of similar areas in their respective canvases. The size scale below each photo represents 10 mm subdivided into 100 divisions of 0.1 mm (100 µm).
3.4. Microclimate Monitoring
The microclimatic parameters measured by the different sensors exhibit a similar trend for all canvases, although some differences are highlighted in the lighting conditions for canvases 6, 5 and 2. Variations in the received illumination can be observed in canvas 6 between October 2021 and November 2021, reaching a maximum value of 20 Lux. During this period, all other canvases appear to have been kept completely in the dark. In the period between December 2021 and May 2022, canvas 2 showed a constant Lux value of 20, while canvases 5, 6 and 9 showed values of Lux = 0, indicating that they remain completely in the dark. In the period between May 2022 and mid-September 2022, canvas 9 showed a constant value of Lux = 19.7, canvas 2 showed a constant value of Lux = 20, canvas 5 showed a constant value of 11.8 Lux, and canvas 6 showed a constant value of 0 Lux. The observed values that differ from the condition of darkness are related to cleaning and maintenance operations within the museum’s storage space. Additionally, the busy activity of an important museum like MAXXI, especially during the various operations that precede and follow the display of new exhibitions, contribute to these variations.
In the period between September 2021 and September 2022, the temperature ranged between a maximum mean value of 22.9 °C and a minimum mean value of 18.7 °C for canvas 9; a maximum mean value of 23.2 °C and minimum mean value of 18.5 °C for canvas 2; a maximum mean value of 23.6 °C and minimum mean value of 18.7 °C for canvas 5; and a maximum mean value of 23.6 °C and minimum mean value of 19.1 °C for canvas 6. Overall, the temperatures for the entire period of one year considered, from September 2021 to September 2022, range from a maximum value of 23.6 °C and a minimum value of 19 °C, with a difference of 4.5 °C.
Regarding relative humidity, the microclimatic sensors registered a maximum mean value of 65.3% and minimum mean value of 42% for canvas 9. Canvas 2 showed a maximum mean value of 66.2% and minimum mean value of 43.6%, while canvas 5 showed a maximum mean value of 68% and minimum mean value of 42.3%. Canvas 6 exhibited a maximum mean value of 69% and minimum mean value of 43%. Overall, the relative humidity ranged from a maximum value of 69% to a minimum value of 43.6% throughout the study period. Such variations are connected to the type of storage dehumidification technology. The relative humidity measurements have been fluctuating with an average of 60 ± 10.
Table 5 shows the trends in temperature (T), relative humidity (UR%), and lighting acquired for the different canvases during the various monitoring campaigns.

Table 5.
Trends in temperature (Temp), relative humidity (UR%), and lighting (Lux) for the several canvases during the different monitoring campaigns.
3.5. Bioluminometer
The average values measured (in the right corner) during the December 2021 and May 2022 monitoring campaign for the different paintings (Table 6), both on the front and back, define a progressive decrease in adenosine triphosphate (ATP) molecules. This implies a lower presence of living cells on the canvases compared to the measurements obtained in September 2021. The reduction is high and most noticeable during the period between December 2021 and May 2022.

Table 6.
ATP values expressed as RLU (relative light units) measured in the canvases in subsequent monitoring campaigns in the same area.
The average values obtained in September 2022 showed an increase in ATP, compared to the measurements taken in May 2022, which can be correlated with increased microbial vitality on the canvases. The phenomenon is more intense for the fronts of canvases 5, 9 and 2. In comparison to the values recorded at the beginning of the monitoring campaign, the most significant reduction in ATP is observed on the back of the canvases: a residual 30% on canvases 5 and 2, 40% on canvas 9 and 50% on canvas 6.
3.6. Spectrocolorimetric Analysis
The Table 7 reported the chromatic variations defined in the four monitoring campaigns. Canvases 5 and 9 from the data obtained by spectrocolorimetric analysis during the December 2021 monitoring showed a high alteration in chromatic parameters compared to the values obtained during the September 2021 campaign. Canvas 9 increases the component of red (a*) and brightness (L*), whereas canvas 5 is characterized primarily by an increase in color towards yellow tones (b*).

Table 7.
Spectrocolorimetric value acquired during the four different monitoring campaigns.
The total color variation (∆Eab) was calculated as the difference in hue parameters between September 2021 and December 2021 to determine whether the color change is perceptible to the naked eye. Values of ∆Eab greater than 5, as seen in canvases 5 and 9, are associated with macroscopically detectable color differences.
In the data obtained during the May 2022 monitoring, canvases 6, 2 and 5 are characterized by a high variation in color parameters, especially on the rear compared to the values acquired on the back during the December 2021 monitoring. In canvas 2, the component of red (a*), yellow (b*) and brightness (L*) increases on the front, while on the back of canvas 6 there is a noticeable decrease in brilliance (L *). A similar phenomenon occurs on the back of canvas 2, along with a reduction in the blue component (b*). Although the front of canvas 9 does not undergo significant changes compared to the December 2021 monitoring, the rear side shows a decrease in brightness (L*) and an increase in the red component (a*), though less significant. Canvas 5 shows a sharper increase in the L* component on the front, along with a decrease in the blue component (b*). On the back of canvas 5, however, a reduction in the L* component and a significant shift towards yellow tones (b*) are observed. The ∆Eab calculated between the values of December 2021 and May 2022 further highlight the change in color perception on the back of all canvases, while the front maintains a difference in hue parameters not perceptible by naked eye.
In the data collected in the September 2022 monitoring campaign, the biggest differences, compared to the May 2022 monitoring, can be found in the back of canvases 6 and 5. These canvases are characterized by a high variation in the L* component, relative to brightness, and a light-yellow tone (b*). Canvas 2 also shows a variation in brightness towards brighter tones on the back. The ΔEab values calculated between May 2022 and September 2022 monitoring highlight a change in surface chroma, observable with the naked eye (∆Eab* > 5). This is particularly evident in the back of canvas 6, both in the front and back of canvas 2, and in the rear of canvas 5. Canvas 9 does not show a detectable change in chroma (∆Eab < 5), retaining the appearance observed in the previous May 2022 monitoring campaign.
The monitoring carried out on 22 December 2021 showed a decrease, compared to the state of preservation of canvases studied in September 2021, and a change in the chromatic value of the microbial biofilm, for canvases 2, 5 and 9. Photographic documentation has allowed the documentation of such a transformation, which, from the analysis in optical microscopy, is due to the turn towards more brown and yellow tones of the color of the surface of the canvases. This result is confirmed by the data collected using spectrocolorimetry and is due to the increase in the red tone and brightness in canvas 9 and by the increase in the yellow tone in canvas 5. In areas of canvas 2 subject to colorimetric analysis, the color variation was limited, probably due to the presence on the surface of soil residues. The data from the bioluminometer define, in all of the artworks under consideration, a high decrease in the vitality of the microorganisms in comparison to September 2021. We can assume that the change in environmental conditions due to the move to the museum storage, and in particular the absence of light, is the limiting factor of growth for the photosynthetic biofilm elements and the cause of the observed variations. Canvas 6 maintained a more similar conservative state with respect to September.
The monitoring carried out in September 2022 showed, compared to the data collected in May 2022, a slight increase in microbial contamination on all artworks, defined by data gathered through the bioluminometer and from observations at the optical microscope. The analysis in spectrocolorimetry highlights this variation compared to the previous condition with an increase in brightness on the front of canvas 2 and the definition of greater yellow tones in the backs of canvases 6, 2, and 5. Photographs have only partially documented this transformation. The microclimate parameters highlight how the canvases have undergone illumination during maintaining operation of the storage spaces, which may have increased the vitality of the photosynthetic component of the microbial consortium.
4. Conclusions
The monitoring process has provided invaluable insights into the dynamic evolution of Vitone’s artworks. The microorganisms have played an integral role in the creation of these distinctive artworks and cannot be eliminated, aligning with the artist’s conceptual vision. However, alterations in the exhibition environment cause climatic fluctuations in room conditions, disturbing the delicate equilibrium of the living microbial community.
Moreover, when these artworks are kept in museum storage, multifaceted issues emerge, impacting the preservation status of the objects. The resilience of fungi and bacteria in generating spores, which are highly resistant life forms sensitive to thermo-hygrometric fluctuations, makes complete eradication unfeasible.
Considering the diverse materials co-located within storage areas, setting temperature and relative humidity parameters within narrow ranges becomes challenging to ensure optimal conservation for all materials.
Currently, to protect the canvases within the museum’s storage rooms and prevent spore and microorganism dispersion through air movement, a careful approach involves wrapping the canvases in a double layer of Tyvek® by DuPont, Wilmington, DE, USA. This method effectively isolates the materials from the surrounding environment without causing condensation or drastic changes in thermo-hygrometric conditions [24]. A different strategy should be considered to control lighting effects on the microbial consortium and prevent the chromatic variation of artworks’ aspects.
The primary goal of this study was to comprehend how these artworks are affected by preservation conditions during museum storage, stressing the importance of evaluating possible changes in the microbial consortium while ensuring the safety of other artworks and visitors. A treatment capable of mitigating and, if possible, eradicating fluctuations in the microbial community should be pursued. To address this complex scenario and uphold the unique essence of the artworks, a defined preservation strategy is crucial. One proposed strategy could involve dedicating a specific museum area for the exhibition and storage for these artworks. A more effective strategy could be to “crystallize” the pattern of microorganisms using a specific coating. In this direction, the authors are carrying out further experiments with the aim of devitalizing the biofilm and binding the pattern using a finishing varnish suitable for the musealization of paintings.
These strategies aspire not only to conserve the artworks but also to safeguard the cultural and artistic legacy they embody.
Author Contributions
Conceptualization, A.M., F.P., S.B. and V.F.; methodology, C.A., A.M., S.M. and T.d.C.; validation, F.P. and T.d.C.; formal analysis, A.M., C.A. and C.Z.; investigation, A.M., C.Z., C.A. and S.M. resources, S.B. and V.F.; data curation, T.d.C.; writing—original draft preparation, C.Z. and A.M., writing—review and editing, F.P. and T.d.C.; supervision, A.M., S.B. and V.F.; project administration, S.B., V.F. and A.M. All authors have read and agreed to the published version of the manuscript.
Funding
This research received no external funding.
Institutional Review Board Statement
Not applicable.
Informed Consent Statement
Not applicable.
Data Availability Statement
Data are contained within the article.
Acknowledgments
The authors would like to thank the directors of both institutes for their support for the project: Andrea Bruciati, Alessandro Giuli. Special thanks go to the following colleagues for their contribution and time to this project: Chiara Biribicchi, Helene Aureli, Sara Capriotti, Irene Angela Colasanti, Giulia Floris, Davide Bertolini, and Clelia Isca.
Conflicts of Interest
The author Camilla Zaratti was employed by the company Lab4green. The remaining authors declare that the research was conducted in the absence of any commercial or financial relationships that could be construed as a potential conflict of interest.
References
- Dykstra, S. The Artist’s Intentions and the Intentional Fallacy in Fine Arts Conservation. J. Am. Inst. Conserv. 1996, 35, 197–218. [Google Scholar] [CrossRef]
- Vidović, K.; Hočevar, S.; Menart, E.; Drventić, I.; Grgić, I.; Kroflič, A. Impact of Air Pollution on Outdoor Cultural Heritage Objects and Decoding the Role of Particulate Matter: A Critical Review. In Environmental Science and Pollution Research; Springer Science and Business Media: Berlin/Heidelberg, Germany, 2022; pp. 46405–46437. [Google Scholar] [CrossRef]
- Van Grieken, R.; Delalieux, F.; Gysels, K. Cultural Heritage and the Environment. Pure Appl. Chem. 1998, 70, 2327–2331. [Google Scholar] [CrossRef]
- Arino, X.; Gómez-Bolea, A. Effects of Climatic Change on Microorganisms Colonizing Cultural Heritage Stone Materials. 2010. Available online: https://www.researchgate.net/publication/304373432 (accessed on 20 November 2023).
- Sesana, E.; Gagnon, A.S.; Ciantelli, C.; Cassar, J.A.; Hughes, J.J. Climate Change Impacts on Cultural Heritage: A Literature Review. In Wiley Interdisciplinary Reviews: Climate Change; John Wiley and Sons Inc.: Hoboken, NJ, USA, 2021. [Google Scholar] [CrossRef]
- Ding, X.; Lan, W.; Yan, A.; Li, Y.; Katayama, Y.; Gu, J.D. Microbiome Characteristics and the Key Biochemical Reactions Identified on Stone World Cultural Heritage under Different Climate Conditions. J. Environ. Manag. 2022, 302, 114041. [Google Scholar] [CrossRef] [PubMed]
- Joseph, E. Microorganisms in the Deterioration and Preservation of Cultural Heritage; Springer International Publishing: Cham, Switzerland, 2021. [Google Scholar] [CrossRef]
- Dakal, T.C.; Cameotra, S.S. Microbially Induced Deterioration of Architectural Heritages: Routes and Mechanisms Involved. In Environmental Sciences Europe; Springer: Berlin/Heidelberg, Germany, 2012. [Google Scholar] [CrossRef]
- Cappitelli, F.; Cattò, C.; Villa, F. The Control of Cultural Heritage Microbial Deterioration. Microorganisms 2020, 8, 1542. [Google Scholar] [CrossRef] [PubMed]
- Valentín, N. Valentín Microbial Contamination in Archives and Museums: Health Hazards and Preventive Strategies Using Air Ventilation Systems Contribution to the Experts’ Roundtable on Sustainable Climate Management Strategies, Held in Microbial Contamination in Archives and Museums: Health Hazards and Preventive Strategies Using Air Ventilation Systems. 2007. Available online: http://www.getty.edu/conservation/science/climate/ (accessed on 20 November 2023).
- Sterflinger, K.; Pinzari, F. The Revenge of Time: Fungal Deterioration of Cultural Heritage with Particular Reference to Books, Paper and Parchment. Environ. Microbiol. 2012, 14, 559–566. [Google Scholar] [CrossRef] [PubMed]
- Sterflinger, K. Fungi: Their Role in Deterioration of Cultural Heritage. Fungal Biol. Rev. 2010, 24, 47–55. [Google Scholar] [CrossRef]
- Marcelli, A.; Sebastianelli, M.; Conte, A.; Lucci, F.; Della Ventura, G. Micro-Climatic Investigation and Particulate Detection in Indoor Environments: The Case of the Historical Museum of Bersaglieri in Rome. Rend. Lincei. Sci. Fis. Nat. 2020, 31, 807–817. [Google Scholar] [CrossRef]
- Getty Conservation Institute. Collection Environments Issue. Fall 2018. 2018. Available online: www.getty.edu/conservation (accessed on 21 November 2023).
- Morris, P. Museum Collections Management Handbook. In California State Parks Museum Services Section: Archaeology, 2nd ed.; California State Parks Museum Services Section Archaeology, History and Museums Division: McClellan, CA, USA, 2001. [Google Scholar]
- Slocum, N. Digital Commons at Buffalo State Museum Studies Theses History and Social Studies Education Toxins in the Collection: Museum Awareness and Protection. 2018. Available online: http://digitalcommons.buffalostate.edu/museumstudies_theseshttp://digitalcommons.buffalostate.edu/museumstudies_theses/16 (accessed on 21 November 2023).
- Ankersmit, B.; Stappers, M.H.L.; Kramer, R. Guideline in Jeopardy: Observations on the Application of the ASHRAE Chapter on Climate Control in Museums. Stud. Conserv. 2018, 63 (Suppl. 1), 1–7. [Google Scholar] [CrossRef]
- Atkinson, J.K. Environmental Conditions for the Safeguarding of Collections: A Background to the Current Debate on the Control of Relative Humidity and Temperature. Stud. Conserv. 2014, 59, 205–212. [Google Scholar] [CrossRef]
- Aiken, Z.A.; Wilson, M.; Pratten, J. Evaluation of ATP Bioluminescence Assays for Potential Use in a Hospital Setting. Infect. Control. Hosp. Epidemiol. 2011, 32, 507–509. [Google Scholar] [CrossRef] [PubMed]
- Garside, P.; Hanson, L. A Systematic Approach to Selecting Inexpensive Conservation Storage Solutions. J. Conserv. Mus. Stud. 2011, 57, 26. [Google Scholar] [CrossRef]
- Stokes, M.; Fairchild, M.D.; Berns, R.S. Precision Requirements for Digital Color Reproduction. ACM Trans. Graph. 1992, 11, 406–422. [Google Scholar] [CrossRef]
- Hill, T.R. Comparative analysis of the quantization of colour spaces on the basis of the CIELAB colour-difference formula. ACM Trans. Graph. 1997, 16, 109–154. [Google Scholar] [CrossRef]
- Wen, Y.-W.; Ng, M.K.; Huang, Y.-M. Efficient Total Variation Minimization Methods for Color Image Restoration. IEEE Trans. Image Process. 2008, 17, 2081–2088. [Google Scholar] [CrossRef] [PubMed]
- Karydis, C.; Kyriazi, E.; Staka, C.A. Clothed Wax Effigies: Construction Materials, Challenges and Suggestions for Preventive Conservation. Conservar. Patrimonio. 2021, 36, 62–81. [Google Scholar] [CrossRef]
Disclaimer/Publisher’s Note: The statements, opinions and data contained in all publications are solely those of the individual author(s) and contributor(s) and not of MDPI and/or the editor(s). MDPI and/or the editor(s) disclaim responsibility for any injury to people or property resulting from any ideas, methods, instructions or products referred to in the content. |
© 2024 by the authors. Licensee MDPI, Basel, Switzerland. This article is an open access article distributed under the terms and conditions of the Creative Commons Attribution (CC BY) license (https://creativecommons.org/licenses/by/4.0/).





















































